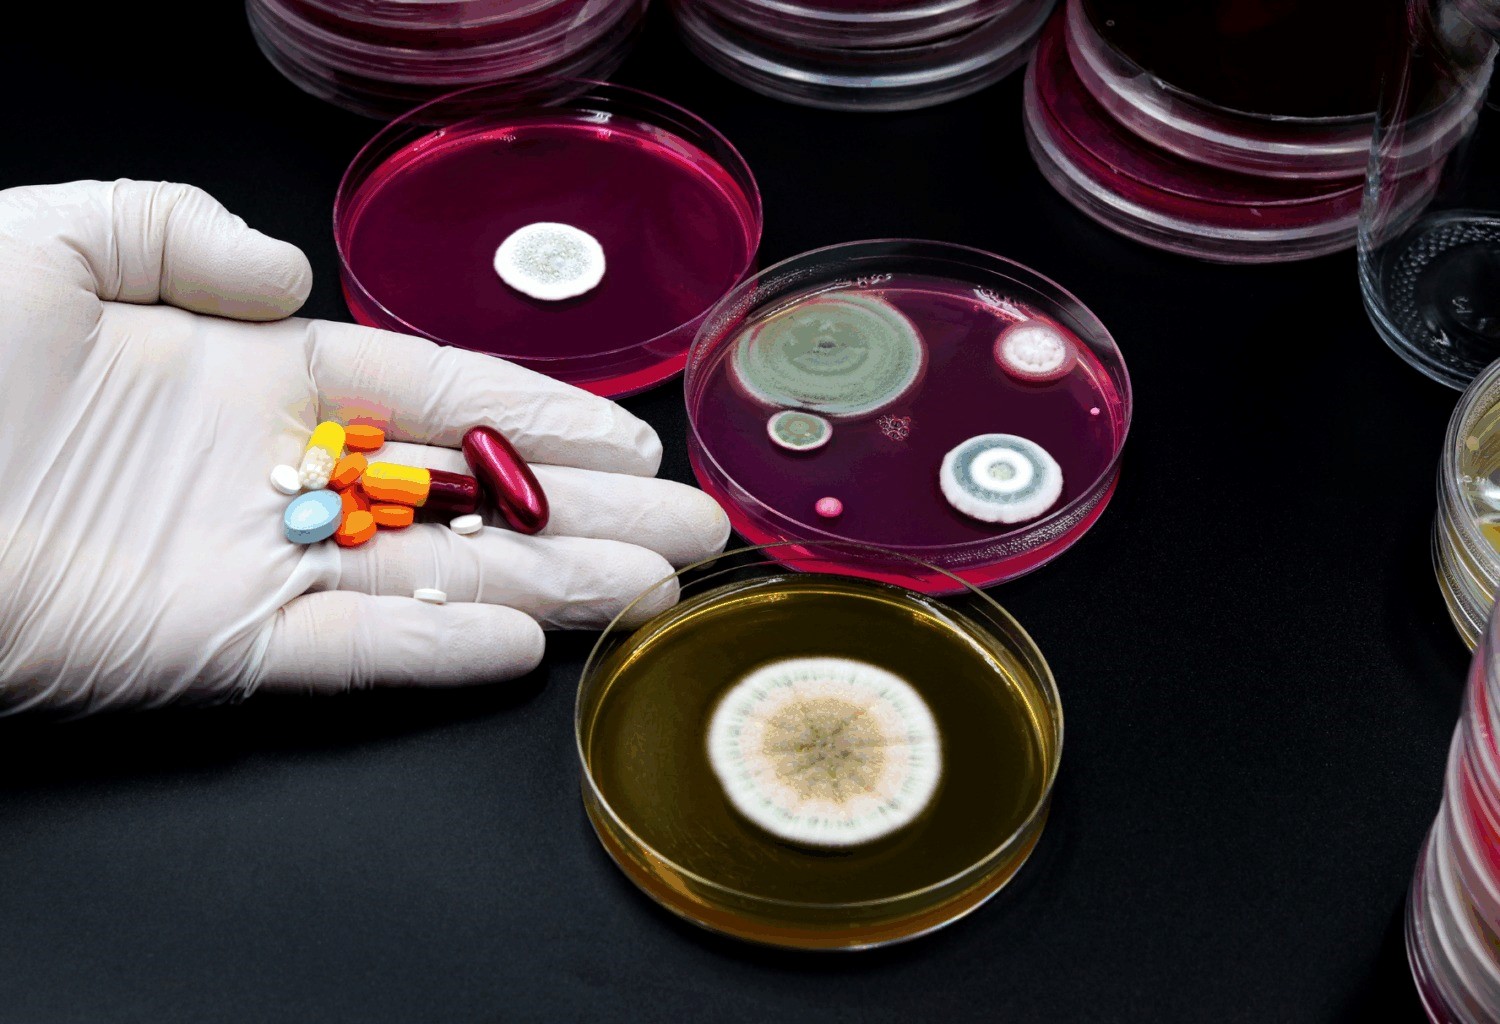

The 60M Bet on Super-Antibiotics That Could Save Millions
Unlike past funding announcements, this represents a restoration of an industry that is desperately in need of funding. The financial realities associated with developing antibiotics have deterred all big pharma companies from entering the market for many years.
Now, let's take a look at why this announcement should be of interest to businesses, health systems, and indeed the global economy; also what it means for the future.
Why Gram-Negative Bacteria Are the Real Villain
Gram-negative organisms such as E. coli and Pseudomonas make up some of the most challenging groups of antibiotic resistant organisms and they are responsible for approximately 5 million deaths each year from antibiotic resistant infections around the world. The unique structure of the cell wall of Gram-negative bacteria creates a double-layered barrier which protects them from many of the existing antibiotics and promotes the production of multidrug-resistant organisms. In economic terms, these organisms are responsible for over $1 trillion in annual economic losses globally due to their impact on healthcare facilities, agricultural operations, and supply chains.
The focus of the Gr-ADI consortium is to develop new methods to combat the challenges presented by Gram-negative bacteria through novel drug discovery approaches. The program has been established as a multi-country, multi-institutional collaboration involving the funding of 18 projects across 17 countries to identify new approaches for the treatment of these pathogens. The Gr-ADI initiative is based on the idea that collaborative efforts to develop new antibiotics must include countries that suffer the highest burdens of antimicrobial resistance, such as Ghana, South Africa, and Brazil, in order to be successful in overcoming the challenges that exist globally with the treatment of infected patients with Gram-negative bacteria.
The Power of Unlikely Allies and Open Data
Why is Gr-ADI unique? It is a new type of consortium that allows researchers to share their data with funders without the restrictions that are placed on other organizations (no proprietary grudges and no silos). RTI International manages Gr-ADI, which has included Gates and Wellcome's existing grantees and will be expanding as Gr-ADI adds more projects in the future.
Consider the market analysis for antibiotic resistance, since Big Pharma (major pharmaceutical companies) is no longer investing in antibiotics;
- It costs upwards of $1B (but only after many years TOPS), just to get an antibiotic approved! The maximum sales for each antibiotic sold after resistance develops, is usually less than $50 million per year.
- Philanthropy funds early-stage programs (provide funding) while they look for private capital later.
- To an investor looking to invest in biotech, you should now realize AMR is not just a fad; it is a $1 trillion dollar opportunity that is missing in the market.
AI and Tech: Accelerating the Hunt
Gr-ADI did not rely solely on trial and error at the time of their study. Several of the projects funded by the Gr-ADI incorporate AI and other tech-enabled solutions to identify antibiotics with greater effectiveness, saving several years off of the time required from identifying to releasing an antibiotic. Over 500 proposals were submitted for review through the Grand Challenges platform that have the potential to be game changers; these are projects leveraging AI to accelerate drug development and discovery - these submissions have received funding. AI's infusion into pharma, for example, speed protein folding, virtual screening, and drug development, has been timely as seen with other AI technologies being used in drug development.
Despite advancements, the challenge of advancing the technology and making them commercially viable will continue. Gr-ADI's first round of funding($60 million) from the initial three-year funding of $300 million (in partnership with VCs) in 2024. Low-income and middle-income countries are the focus for Gr-ADI grantees, as these countries provide technical resources to guide research for equitable access vs profit-driven, as stated by Alexander Pym, CEO of Gr-ADI.
Business Implications Beyond the Lab
Healthcare executives and investors understand that the problem of Antimicrobial Resistance (AMR) is a threat to the supply chain. The ongoing pandemic has created a huge burden on hospitals, which are now experiencing increased patient length-of-stay and associated costs.
Similarly, agribusinesses are contending with livestock pathogens that have developed resistance to drugs. Countries like India spend approximately up to 30% of their healthcare budget on treating infections. Therefore, this will lead to a more stabilised operation in such countries and moreover, reduce the insurance premiums paid by the people over time.
It's necessary to understand the humanitarian angle of this issue. Along with the nurses caring for patients with such untreatable infections and families mourning the loss of loved ones from simple UTIs. If these efforts prove to be successful, then they can help restore confidence in offering routine care for various medical procedures ranging from C-sections to chemotherapy.
But execution will determine if this initiative succeeds: only if we can continue to share open access to data and not allow for the emergence of intellectual property (IP) barriers again.
A Model for Tomorrow's C milrises
The creation of Global Antibiotic Development Initiative (Gr-ADI) is coming about at an ideal time in the wake of the COVID-19 pandemic, as the problem of antibiotic resistance is reaching epidemic levels and escalating at an alarming rate globally. Gr-ADI will create an opportunity to establish working relations around the world and to integrate advanced technological capabilities for addressing "silent" threats, such as climate-induced diseases. Furthermore, in addition to being a source of funding, Gr-ADI represents a major cultural change in the way we look at working collaboratively to address the challenge of AMR in a time of unstructured innovation.
So will Gr-ADI create super antibiotics? If recent trends continue, it would appear likely, as many experts from various industries are converging their efforts on Gram-negative organisms. Those businesses that recognize the value of early partnerships (i.e., diagnostics companies or artificial intelligence platforms) will have a significant competitive advantage. All other businesses will be forced to adapt when superbugs are upon them.
In the end, $60 million feels modest against AMR's toll, but it's momentum. Watch this space; the next breakthrough might just rewrite the rules.

